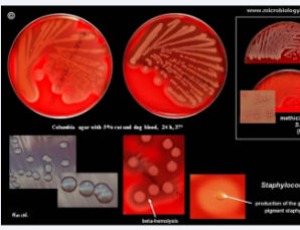

Recent Articles
-
May 30, 2026 Research Article
 Abstract Background: Bovine tuberculosis (bTB), caused by Mycobacterium bovis, is a chronic, debilitating zoonotic disease of major global importance, affecting both animals and humans, particularly in low- and middle-income countries especially in developi.....
Abstract Background: Bovine tuberculosis (bTB), caused by Mycobacterium bovis, is a chronic, debilitating zoonotic disease of major global importance, affecting both animals and humans, particularly in low- and middle-income countries especially in developi..... -
April 22, 2026 Review Article
 Abstract Brucellosis is an infectious, contagious and zoonotic disease affecting humans and many animal species, including camels. In Africa, studies on camel brucellosis are mainly based on serological surveys, while studies based on bacterial isolation or.....
Abstract Brucellosis is an infectious, contagious and zoonotic disease affecting humans and many animal species, including camels. In Africa, studies on camel brucellosis are mainly based on serological surveys, while studies based on bacterial isolation or..... -
April 22, 2026 Short Communication
 Abstract Preliminary in vitro trial was conducted to assess the licicidal potentials of extracts of Allium sativum against poultry wing louse, Lipeurus caponis through filter paper bioassay. The ethanolic extract of A. saiivum exhibited lousicidal properties .....
Abstract Preliminary in vitro trial was conducted to assess the licicidal potentials of extracts of Allium sativum against poultry wing louse, Lipeurus caponis through filter paper bioassay. The ethanolic extract of A. saiivum exhibited lousicidal properties ..... -
March 12, 2026 Review Article
 Abstract Mastitis is defined as inflammation of the parenchymal tissue of the mammary gland, regardless of its cause. Mastitis cases with unidentified etiology have drawn attention to the possible role of viruses. Viruses whose activity has been detected .....
Abstract Mastitis is defined as inflammation of the parenchymal tissue of the mammary gland, regardless of its cause. Mastitis cases with unidentified etiology have drawn attention to the possible role of viruses. Viruses whose activity has been detected ..... -
March 04, 2026 Opinion Article
 Abstract Mycobacterium avium subspecies paratuberculosis (MAP) is a significant pathogen of herbivores and a less prominent pathogen in humans.
Abstract Mycobacterium avium subspecies paratuberculosis (MAP) is a significant pathogen of herbivores and a less prominent pathogen in humans. -
February 01, 2026 Review Article
 Abstract Equine endoparasites continue to pose a significant threat to horse health, performance, and productivity worldwide. The most prevalent and pathogenic species—cyathostomins , large Strongyles, Parascaris, Dictyocaulus, Oxyuris, and Gastrophilus�.....
Abstract Equine endoparasites continue to pose a significant threat to horse health, performance, and productivity worldwide. The most prevalent and pathogenic species—cyathostomins , large Strongyles, Parascaris, Dictyocaulus, Oxyuris, and Gastrophilus�..... -
April 22, 2018 Review Article
 Abstract Caseous lymphadenitis is one of the most significant zoonotic diseases caused by C. pseudotuberculosis with enormous economic losses in animal industry worldwide. The global burden of its incidence in animal populations remains at an alarming rate......
Abstract Caseous lymphadenitis is one of the most significant zoonotic diseases caused by C. pseudotuberculosis with enormous economic losses in animal industry worldwide. The global burden of its incidence in animal populations remains at an alarming rate...... -
August 28, 2024 Research Article
 Abstract Methane is one of the greenhouse gases. Methanogens can produce methane by metabolites of rumen microorganisms such as fungi and ciliates, that is, and the emission of methane in the process of culture is closely related to rumen microbial community......
Abstract Methane is one of the greenhouse gases. Methanogens can produce methane by metabolites of rumen microorganisms such as fungi and ciliates, that is, and the emission of methane in the process of culture is closely related to rumen microbial community...... -
August 13, 2020 Research Article
 Abstract Our goal was to assess gabapentin dosage and tolerability in dogs taking it for chronic pain. We retrospectively analyzed the medical records of 240 dogs taking gabapentin for chronic pain and systematically assessed: patient signalment, definitive d.....
Abstract Our goal was to assess gabapentin dosage and tolerability in dogs taking it for chronic pain. We retrospectively analyzed the medical records of 240 dogs taking gabapentin for chronic pain and systematically assessed: patient signalment, definitive d..... -
July 28, 2020 Review Article
Abstract Present review was carried out in order to explore the geographical distribution, prevalence and resistance mechanism of Staphylococcus aureus against methicillin worldwide. Study indicated that Staphylococcus aureus infections in pets are a common p.....
Abstract Present review was carried out in order to explore the geographical distribution, prevalence and resistance mechanism of Staphylococcus aureus against methicillin worldwide. Study indicated that Staphylococcus aureus infections in pets are a common p..... -
September 11, 2020 Research Article
-
February 10, 2019 Research Article
 Abstract A cross sectional study was conducted from October 2017 to March 2018 with the objectives of determining the prevalence and economic importance of ovine fasciolosis in Ambo restaurant. Coprological and postmortem examinations were employed to determi.....
Abstract A cross sectional study was conducted from October 2017 to March 2018 with the objectives of determining the prevalence and economic importance of ovine fasciolosis in Ambo restaurant. Coprological and postmortem examinations were employed to determi..... -
February 06, 2019 Short Communication
 Abstract The aim of this paper is investigate the effects of rainfall in urban leptospiroses cases in a one the most largest city in the world, Rio de Janeiro/Brazil, in 2007 to 2017 period. Urban Leptospirosis study is relevant to public health because of it.....
Abstract The aim of this paper is investigate the effects of rainfall in urban leptospiroses cases in a one the most largest city in the world, Rio de Janeiro/Brazil, in 2007 to 2017 period. Urban Leptospirosis study is relevant to public health because of it..... -
January 31, 2019 Research Article
 Abstract The ability to take repeated, in situ blood glucose readings using a hand-held glucometer has considerable utility for researchers. These devices are small, affordable, and impose minimal stress on test subjects, yet their reliability is uncertain. W.....
Abstract The ability to take repeated, in situ blood glucose readings using a hand-held glucometer has considerable utility for researchers. These devices are small, affordable, and impose minimal stress on test subjects, yet their reliability is uncertain. W..... -
January 24, 2019 Research Article
 Abstract A cross-sectional study was conducted from November 2017 to March 2018 in Gamo Gofa Zone, Demba Gofa District in SNNPR, to determine the prevalence of skin diseases in sheep and goats and to identify dominant risk factors associated with skin disease.....
Abstract A cross-sectional study was conducted from November 2017 to March 2018 in Gamo Gofa Zone, Demba Gofa District in SNNPR, to determine the prevalence of skin diseases in sheep and goats and to identify dominant risk factors associated with skin disease..... -
January 24, 2019 Research Article
 Abstract Cryptosporidium spp. are major protozoal parasites infecting dairy cattle and cryptosporidiosis is a leading cause of morbidity in dairy calves. The objective of this study was to determine the prevalence and intensity of Cryptosporidium spp. infecti.....
Abstract Cryptosporidium spp. are major protozoal parasites infecting dairy cattle and cryptosporidiosis is a leading cause of morbidity in dairy calves. The objective of this study was to determine the prevalence and intensity of Cryptosporidium spp. infecti..... -
December 26, 2018 Research Article
 Abstract This study was aimed to assess the presence of Campylobacter jejuni infection and some of its virulence genes in broiler chickens in New Valley and Assiut provinces, Egypt. The study was conducted on 200 broiler chicken samples which obtained from 12.....
Abstract This study was aimed to assess the presence of Campylobacter jejuni infection and some of its virulence genes in broiler chickens in New Valley and Assiut provinces, Egypt. The study was conducted on 200 broiler chicken samples which obtained from 12..... -
December 26, 2018 Research Article
 Abstract A Coprology based cross sectional study was conducted on poultry coccidiosis of local and exotic breed from April to June, 2018 in and around Jimma town, Oromia regional state, south western Ethiopia. A total of 367 faecal samples were collected from.....
Abstract A Coprology based cross sectional study was conducted on poultry coccidiosis of local and exotic breed from April to June, 2018 in and around Jimma town, Oromia regional state, south western Ethiopia. A total of 367 faecal samples were collected from..... -
September 11, 2018 Editorial
 Abstract Mycotoxins are toxic substances that are produced by several species of fungi when environmental conditions are favorable. Mycotoxins are associated with several ill health syndromes in both animals and humans. Prevention and control are difficult, b.....
Abstract Mycotoxins are toxic substances that are produced by several species of fungi when environmental conditions are favorable. Mycotoxins are associated with several ill health syndromes in both animals and humans. Prevention and control are difficult, b.....










